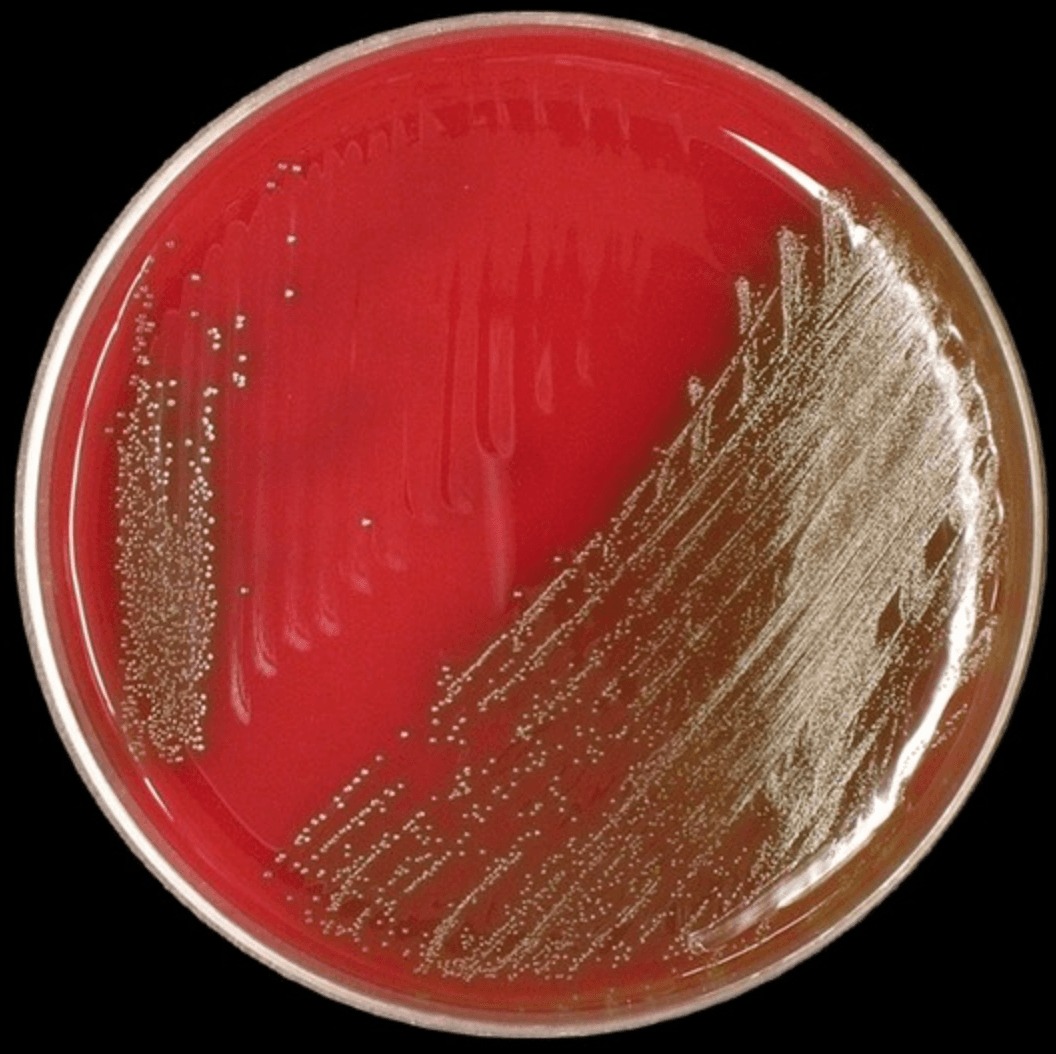
Blood agar plate showing pinpoint alpha-hemolytic colonies of Streptococcus anginosus group with characteristic narrow green halo

The Sweet Smell of Trouble
Clinical Vignette
A 54-year-old man with no significant past medical history presents with four weeks of low-grade fever, drenching night sweats, right upper quadrant discomfort, and a 10-pound unintentional weight loss. He denies recent travel, sick contacts, alcohol use, or any recent dental or surgical procedures. He has not seen a physician in several years and is not up to date on preventive health maintenance.
On examination he is febrile to 38.9°C, heart rate 98 bpm, blood pressure 118/74 mmHg, and oxygen saturation 98% on room air. He appears fatigued and has lost muscle mass. There is tenderness to palpation in the right upper quadrant without peritoneal signs. The liver edge is palpable 3 cm below the costal margin. No splenomegaly, jaundice, or lymphadenopathy is present.
White blood cell count is 15,800/μL with 86% neutrophils and 11 bands. Hemoglobin is 10.4 g/dL (normocytic). Platelet count is 512,000/μL. ESR is 118 mm/hr and CRP is 194 mg/L. Alkaline phosphatase is 312 U/L; AST and ALT are mildly elevated. Total bilirubin is normal. Serum albumin is 2.8 g/dL. CT of the abdomen with contrast reveals an 8 cm multiloculated low-attenuation lesion in the right hepatic lobe with peripheral enhancement and internal septations, consistent with a pyogenic abscess. No pneumobilia is identified. Two sets of blood cultures are drawn before antibiotics are started.
Sheep blood agar: pinpoint alpha-hemolytic colonies with a narrow green zone.
Question 1
Blood cultures flag positive at 36 hours. The microbiology technician notes pinpoint colonies (less than 0.5 mm) on sheep blood agar with a narrow zone of alpha hemolysis and comments on a distinctive sweet, butterscotch-like odor when the plate is uncapped. Gram stain shows gram-positive cocci in short chains and pairs. Which organism is most likely responsible?
Select one option to submit your answer and view live poll results.
Question 2
The organism is identified and susceptibility testing confirms penicillin MIC ≤ 0.12 µg/mL (susceptible). What is the most appropriate management?
Select one option to submit your answer and view live poll results.
References
Molina JM, Leport C, Bure A, Wolff M, Michon C, Vilde JL. Clinical and bacterial features of infections caused by Streptococcus milleri. Scandinavian Journal of Infectious Diseases. 1991;23(5):659-666.
Bert F, Bariou-Lancelin M, Lambert-Zechovsky N. Clinical significance of bacteremia involving the Streptococcus milleri group: 51 cases and review. Clinical Infectious Diseases. 1998;27(2):385-387.
Patel N, Lubinsky AS, Moskovitz M, Chokshi R. Association between Streptococcus anginosus group bacteremia and colorectal cancer: a systematic review. Journal of Clinical Gastroenterology. 2022;56(3):216-224.
Brewer SC, Wunderink RG, Jones CB, Leeper KV. Ventilator-associated pneumonia due to Pseudomonas aeruginosa. Kaplan SL. Streptococcus anginosus group infections. UpToDate. Accessed April 2026.